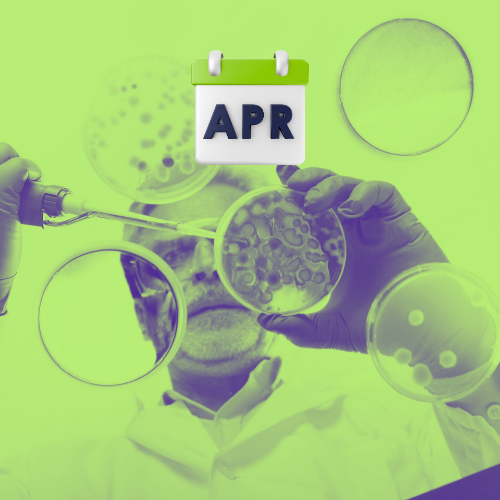

Virtual Engagement Series
Your Strategic Advantage Before the Summit.
The Virtual Engagement Series is the eight-month runway into the Quantum Investment Summit — a curated set of monthly investor briefings that sharpen theses, deepen sector knowledge, and build strategic alignment across the global investor community.
Powered by the Potomac Quantum Innovation Center, curated by Connected DMV, and integrated with JonesTrading’s institutional investor network, the series gives participants a decisive informational advantage heading into the inaugural Summit in September 2026.
Unlock your Access to the Virtual Engagement SEries
Register now to create an account and lock in your seat for the Virtual Engagement Series — your gateway to upcoming invites, insider updates, and every recording and resource once the conversations begin in January.
-

Market Landscape
Quantum investment thesis development and market sizing.
-

Technology Showcase
Quantum sensing and computing commercial applications.
-

Defense & National Security
Quantum for national security applications.
-
Life Sciences & Biotechnology
Quantum in life sciences, including drug discovery and materials science.
-

Financial Services & Risk Management
Quantum optimization for portfolio management and risk.
-

The AI + Quantum Convergence
The intersection driving next-generation applications.
-

Investment Structure & Valuation
Practical Frameworks for quantum company assessment.
-

Summarization & Investor Summit Preview
Recap the virtual series and get a exclusive summit preview ahead of the event.
Who is the Virtual Engagement Series for?
The Virtual Engagement Series is designed for the people who are actively shaping capital deployment, technology adoption, and strategic advantage across frontier markets. If you’re making high-stakes decisions in or around quantum, this series is for you.
-
Investors looking to identify early technical inflection points, understand where scientific readiness meets commercial timing, and get ahead of emerging quantum markets before they mainstream.
-
Funds focused on scaling companies that are moving from research to revenue, and that want a clear signal on which quantum domains are maturing fastest.
-
Strategics in tech, defense, aerospace, energy, finance, biotech, and materials science who need visibility into frontier technologies that will impact their core businesses.
-
Long-horizon, thesis-driven investors who want curated, high-signal insights before building or expanding a quantum portfolio.
-
Firms tracking national security signals, emerging technology markets, and federal funding flows to understand where quantum could move public markets and corporate activity.
-
Buy-side and sell-side advisors who want to understand the deal landscape, upcoming capital needs, and where consolidation or acquisition might occur.
-
Agencies, integrators, and mission-driven organizations who need alignment between technology pipelines and real operational requirements.
-
Industry teams working on long-term technology bets, research roadmaps, or high-value internal use cases who need a credible picture of quantum’s commercial trajectory.